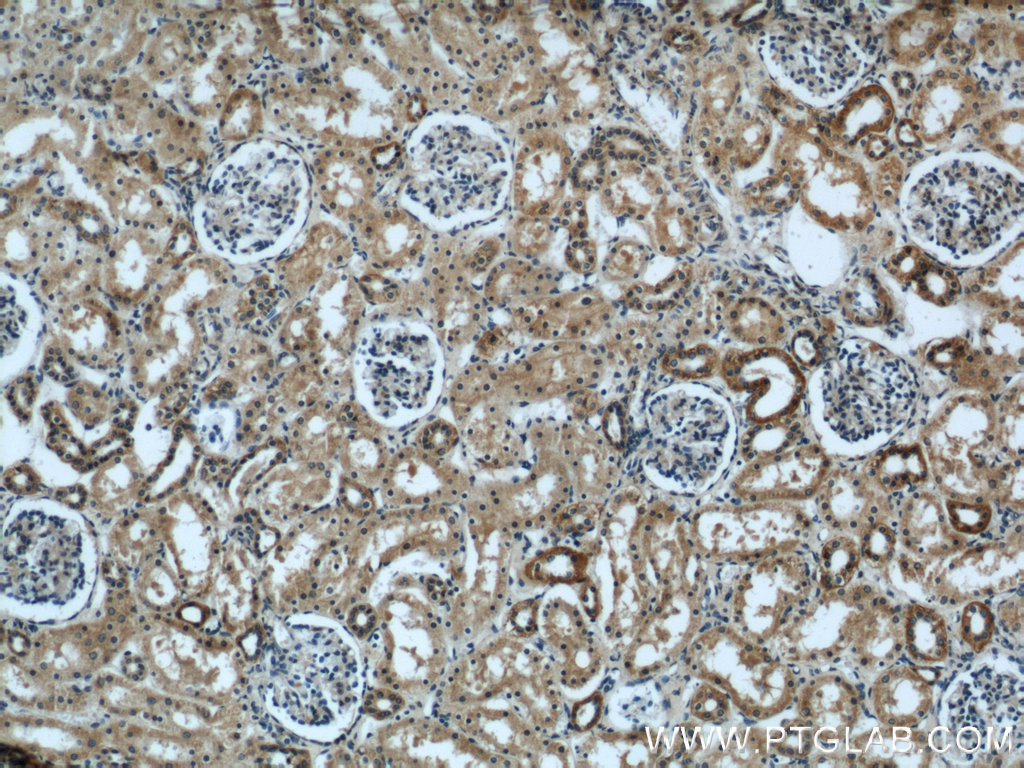

EYA1抗体
产品名称: EYA1抗体
英文名称: EYA1Antibody
产品编号: XY 22658-1
产品价格: null
产品产地: 中国/美国
品牌商标: XYbscience
更新时间: 2023-08-17T09:55:27
使用范围: WB,ELISA,IHC-P,IHC-F,IF
- 联系人 : 徐经理
- 地址 : 上海市闵行莘庄工业区春东路508号A1-2F
- 邮编 : 200612
- 所在区域 : 上海
- 电话 : 152****8802 点击查看
- 传真 : 点击查看
- 邮箱 : shxysw02@163.com
- 二维码 : 点击查看
EYA1抗体
IP = Immunoprecipitation
XY534Hu22 组氨酸丰富糖蛋白(HRG)单克隆抗体 Monoclonal Antibody to Histidine Rich Glycoprotein (HRG) Homo sapiens (Hukl)
XY536Hu22 通用转录因子ⅡA肽1(GTF2A1)单克隆抗体 Monoclonal Antibody to General Transcription Factor IIA, Polypeptide 1 (GTF2A1) Homo sapiens (Hukl)
XY537Hu22 低氧上调节因子1(HYOU1)单克隆抗体 Monoclonal Antibody to Hypoxia Up Regulated 1 (HYOU1) Homo sapiens (Hukl)
XY549Hu22 外皮蛋白(EVPL)单克隆抗体 Monoclonal Antibody to Envoplakin (EVPL) Homo sapiens (Hukl)
XY551Hu22 Janus激酶1(JAK1)单克隆抗体 Monoclonal Antibody to Janus Kinase 1 (JAK1) Homo sapiens (Hukl)
XY553Hu22 角膜蛋白(KERA)单克隆抗体 Monoclonal Antibody to Keratocan (KERA) Homo sapiens (Hukl)
XY554Hu22 驱动蛋白2(KNS2)单克隆抗体 Monoclonal Antibody to Kinesin 2 (KNS2) Homo sapiens (Hukl)
XY559Hu22 吻素1(KISS1)单克隆抗体 Monoclonal Antibody to Kisspeptin 1 (KISS1) Homo sapiens (Hukl)
XY561Hu22 淋巴细胞胞浆蛋白1(LCP1)单克隆抗体 Monoclonal Antibody to Lymphocyte Cytosolic Protein 1 (LCP1) Homo sapiens (Hukl)
XY563Hu22 白细胞衍生趋化因子1(LECT1)单克隆抗体 Monoclonal Antibody to Leukocyte Cell Derived Chemotaxin 1 (LECT1) Homo sapiens (Hukl)
XY564Hu22 天冬酰胺內肽酶(LGMN)单克隆抗体 Monoclonal Antibody to Legumain (LGMN) Homo sapiens (Hukl)
XY568Hu22 兜甲蛋白(LOR)单克隆抗体 Monoclonal Antibody to Loricrin (LOR) Homo sapiens (Hukl)
XY569Hu22 溶血磷脂酸受体1(LPAR1)单克隆抗体 Monoclonal Antibody to Lysophosphatidic Acid Receptor 1 (LPAR1) Homo sapiens (Hukl)
XY576Hu22 催泪蛋白(LACRT)单克隆抗体 Monoclonal Antibody to Lacritin (LACRT) Homo sapiens (Hukl)
XY578Hu22 Pim-1原癌基因(PIM1)单克隆抗体 Monoclonal Antibody to Pim-1 Oncogene (PIM1) Homo sapiens (Hukl)
XY580Hu22 赖氨酰氧化酶(LOX)单克隆抗体 Monoclonal Antibody to Lysyl Oxidase (LOX) Homo sapiens (Hukl)
XY585Hu22 尿皮质素2(UCN2)单克隆抗体 Monoclonal Antibody to Urocortin 2 (UCN2) Homo sapiens (Hukl)
XY586Hu22 线粒体解偶联蛋白2(UCP2)单克隆抗体 Monoclonal Antibody to Uncoupling Protein 2, Mitochondrial (UCP2) Homo sapiens (Hukl)
XY595Hu22 绒毛蛋白1(VIL1)单克隆抗体 Monoclonal Antibody to Villin 1 (VIL1) Homo sapiens (Hukl)
XY596Hu22 血管活性肠肽受体1(VIPR1)单克隆抗体 Monoclonal Antibody to Vasoactive Intestinal Peptide Receptor 1 (VIPR1) Homo sapiens (Hukl)
XY598Hu22 血管非炎性蛋白1(VNN1)单克隆抗体 Monoclonal Antibody to Vanin 1 (VNN1) Homo sapiens (Hukl)
XY600Hu22 牛痘相关激酶1(VRK1)单克隆抗体 Monoclonal Antibody to Vaccinia Related Kinase 1 (VRK1) Homo sapiens (Hukl)
XY603Hu22 血管舒张剂激活磷蛋白(VASP)单克隆抗体 Monoclonal Antibody to Vasodilator Stimulated Phosphoprotein (VASP) Homo sapiens (Hukl)